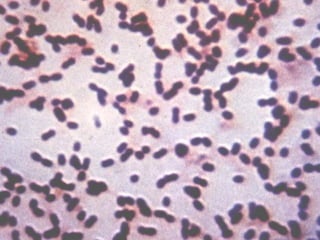

El documento proporciona información sobre las meningitis bacteriana y viral, incluyendo agentes etiológicos comunes, cuadros clínicos, diagnóstico, tratamiento y pronóstico. Describe las bacterias y virus que causan meningitis en recién nacidos, lactantes, niños y adultos, así como las formas de diagnóstico a través del liquido cefalorraquídeo. Explica que el tratamiento para la meningitis bacteriana depende del agente causal y la edad del paciente, y generalmente incluye antib